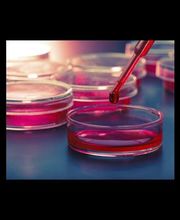
Gallery Cliente

Chiama ora!
Laboratorio Analisi Cliniche Dottoresse Michela De Michele e Fulvia Valente Snc
Ricerca
+39091532245 (Telefono)
+393476298714 (ALTERNATE)
Novità e Offerte
Info
Il Laboratorio di Analisi Cliniche della dr.ssa Michela De Michele e dr.ssa Fulvia Valente è una struttura convenzionata con il S.S.N. che si occupa prevalentemente di diagnostica clinica, di diagnostica di laboratorio e ormonale. Il centro esegue test per l'HIV, esami specialistici, analisi microbiologiche, analisi del sangue e del dosaggio ormonale, tamponi rapidi, tamponi molecolari, pcr, green pass, tamponi antigenici, tamponi salivari, tamponi a domicilio, tamponi per aziende, test sierologici covid 19, anticorpi antispike. Tra i vari servizi offerti, la struttura è a disposizione per effettuare prelievi del sangue e assistenza a domicilio. Il Laboratorio di Analisi Cliniche della dr.ssa Michela De Michele e dr.ssa Fulvia Valente si trova a Palermo.
Orari di apertura
- Lunedì
- 08:00 a 13:00
- Martedì
- 08:00 a 13:00
- Mercoledì
- 08:00 a 13:00
- Giovedì
- 08:00 a 13:00
- Venerdì
- 08:00 a 13:00
- Sabato
- Chiuso
- Domenica
- Chiuso
Settori / Specializzazioni
RicercaGalleria

Mappa
Via Sferracavallo, 122, 90147 Sferracavallo
